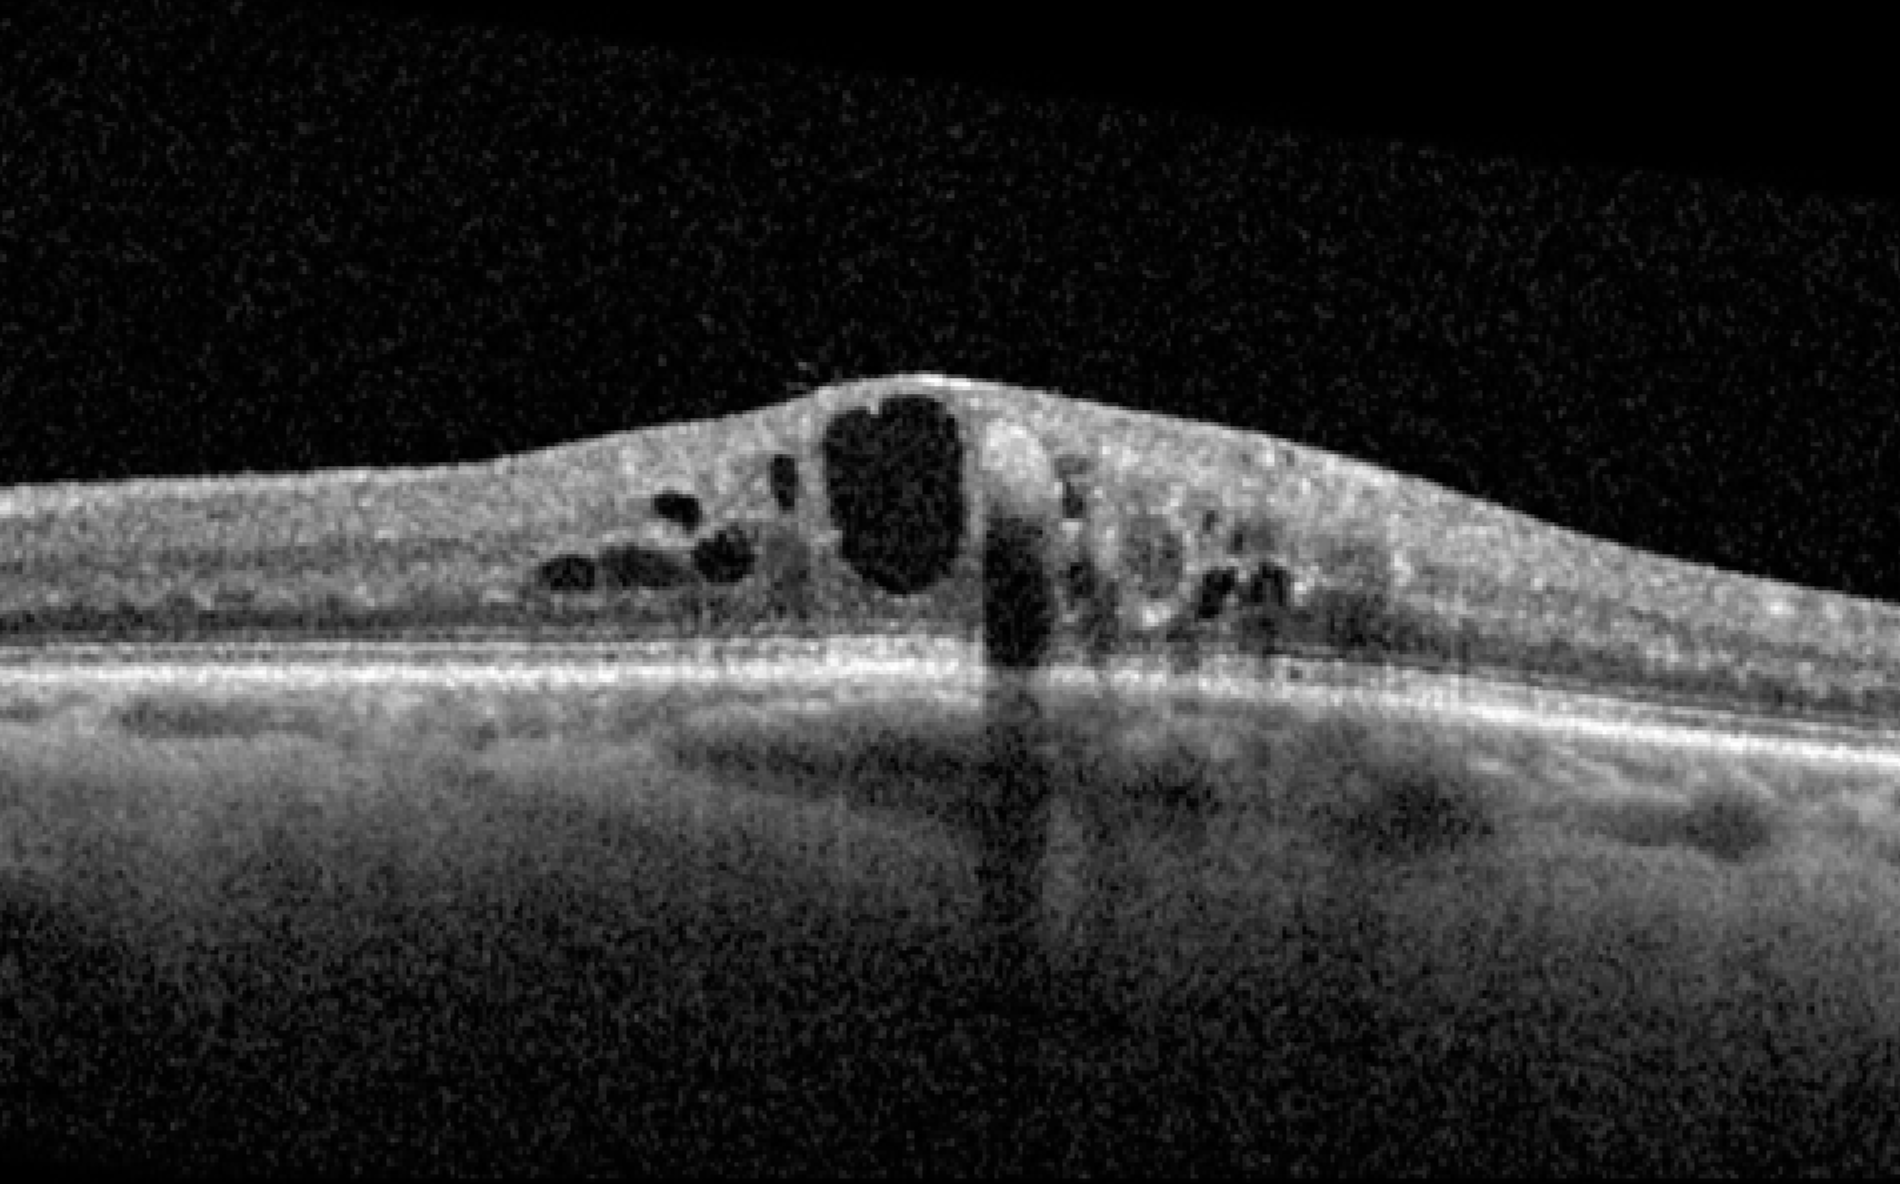
Diabetic Eye disease

Surgical and Clinical Procedures

Cataract Surgery
State-of-the-art cataract extraction technique with placement of a mono- or multifocal intraocular lens.

Pterygium & OSSN
Pterygium surgery with tissue glue to maximise post-operative comfort and improved healing time.
Surgical treatment for ocular surface squamous cell neoplasia (OSSN) also offered.

Glaucoma
Glaucoma monitoring and treatment.
.
Treatment with intraocular pressure lowering lasers (SLT, laser peripheral iridotomy) and minimally invasive glaucoma surgery (MIGS).

Age-Related Macular Degeneration (AMD)
Intravitreal injection for Wet AMD and Advanced Geographic Atrophy.
Diabetic Eye disease
Intravitreal injections and retinal laser to target complications of diabetic retinopathy and maculopathy.

Retinal Vein Occlusion
Intravitreal injection for macular oedema following Retinal Vein Occlusions.

Periocular skin Cancer excision and reconstruction
Subspecialized surgical care for excision of benign and malignant periocular skin lesions with emphasis on cancer clearance and optimal postoperative cosmesis.

Eyelid malposition repair
Surgical treatment for Ectropion / Entropion from age-related changes/sun damage/facial nerve palsy/scar retraction.
.
Upper eyelid blepharoplasty and ptosis repair also offered.

Botox for Facial Spasms
Neuromodulatory drugs for Hemifacial Spasm and Essential Blepharospasm.